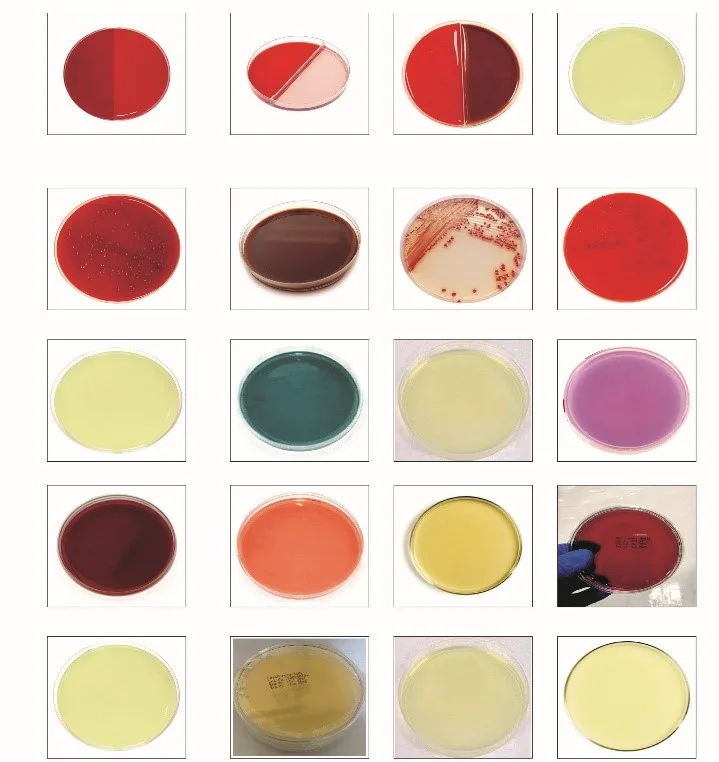

Products
Culture Media Plates
55/90/100 MM
- Bi-Plate (Blood +
Mannitol Salt) Agar Plates
- Bi-Plate (Blood +
MacConkey) Agar Plates
- Bi-Plate (Blood +
Chocolate) Agar Plates
- Brain Heart Infusion
Agar Plates
- Blood Mueller Hinton
Agar Plates
- Cetrimide Agar Plates
- CLED Agar Plates
- Chocolate Agar Plates
- Chrom UTI Agar Plates
- Columbia Agar Plates
- Columbia Agar with 5%
Blood Plates
- Dey-Engley Neutralizing
Agar Plates
- EMB Agar Plates
- Mannitol Salt Agar
Plates
- Mueller Hinton Agar
Plates
- MacConkey Agar Plates
- Nutrient Agar Plates
- PDA Agar Plates
- Reinforced Clostridial
Agar Plates
- R2A Agar Plates
- Sheep Blood Agar Plates
- SCDA Agar Plates
- Sabouraud
Chloramphenicol Agar Plates
- SDA Agar Plates
- Salmonella Shigella Agar
Plates
- TCBS Agar Plates
- XLDA Agar Plates
- Violet Red Bile Glucose
Agar Plates
- SCDA with 1% Glycerol &
Polysorbate 80 Plates
- SCDA with Lecithin &
Polysorbate 80 Plates
- Sheep Blood SCDA Plates